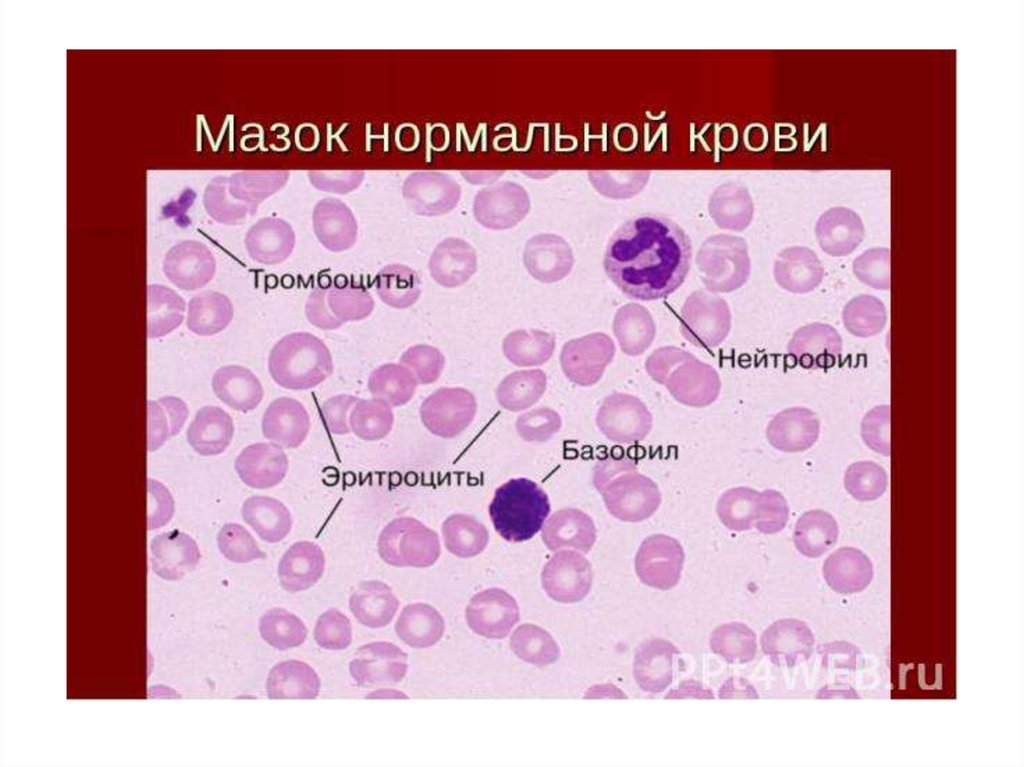

Похожие презентации:
Малярия
1.
2.
3.
4.
5.
6.
7. Малярийный комар
8.
9.
10.
11.
12.
13.
14.
15.
16.
17.
18.
19.
20.
21.
22.
23.
24. Взятие крови на предметное стекло и приготовление мазка
25.
26.
27.
28.
29.
30.
31.
32.
33.
34. Ту Юю. КНР 2015г. Нобелевская премия
35.
36.
37.
38. Защита от комаров
• Ликвидация мест выплода комаровпутем мелиорации или ирригации
анафелогенных водоемов
• Для уничтожения личинок и куколок
комаров применяют пленкообразующие
вещества, высшие жирные спирты,
жирные кислоты
• Используют микробиологический
препарат - бактокурицид
39.
40. Защита от комаров
• Применение реппелентов: «Insect repellent»,содержащих ДЭТА и ДМФ (диметилфталат),
«My-lol», содержащий ДБФ и ДМФ (дибути- и
диметилфталат)
• Засетчивание противомоскитными сетками
окон и дверных проемов в жилых и
служебных помещениях, использование
сетчатых пологов (из терилена),
инсектицидов, содержащих пиретрум («Flit
gun»)
41. Защита от комаров
• Комплекс бонификационных мероприятий,применяют ларвицидные средства в местах
выплода комаров и имагоцидные препараты
для уничтожения комаров в жилых и
хозяйственных помещениях
• Ларвицидные средства –хлорорганические
соединения (ГХЦГ, диэлдрин), нефть, а также
фосфорорганические вещества (малатион,
фенитротион, карбаматы – пропуксур и др.)
42. Защита от комаров
• В целях охраны окружающей среды впоследние годы получили распространение
биологические методы борьбы с личинками
комаров: хемостерилизация, разведение
личинкоядных гидробионтов (рыбки Gambusia
affinis, Lebister,молодь белого амура, карпа),
антагонистов (нематоды типа нерметиновых
Romanomermix culicivorax), патогенных для
личинок грибов (микроспоридии Nosena
algeral) и бактерий B.thuringiensis
43.
44.
• Получены положительные результаты вразработке противомалярийных вакцин –
мерозоитной, шизоитной и в особенности
спорозоитной методом гибритизации с
применением искусственных полипептидов,
повторяющих циркумспорозоитный белок
мембраны спорозоитов. Применение
последнего типа вакцины наиболее
перспективно для предупреждения инвазии
малярийных плазмодиев

Биология
Биология








